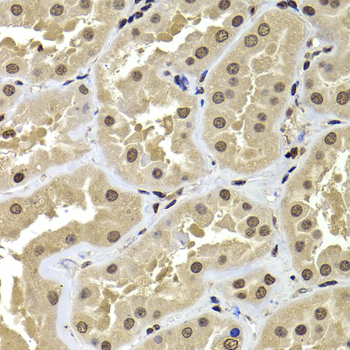
Immunohistochemistry - ACTL6B Polyclonal Antibody

-
Product Name
ACTL6B Polyclonal Antibody
- Documents
-
Description
Polyclonal antibody to ACTL6B
-
Tested applications
WB, IHC, IF
-
Species reactivity
Human, Mouse, Rat
-
Alternative names
ACTL6B antibody; ACTL6 antibody; BAF53B antibody; arpNalpha antibody; actin like 6B antibody
-
Isotype
Rabbit IgG
-
Preparation
Antigen: Recombinant fusion protein containing a sequence corresponding to amino acids 1-280 of human ACTL6B (NP_057272.1).
-
Clonality
Polyclonal
-
Formulation
PBS with 0.02% sodium azide, 50% glycerol, pH7.3.
-
Storage instructions
Store at -20℃. Avoid freeze / thaw cycles.
-
Applications
WB 1:500 - 1:2000
IHC 1:50 - 1:200
IF 1:50 - 1:100 -
Validations

Western blot - ACTL6B Polyclonal Antibody
Western blot analysis of extracts of various cell lines, using ACTL6B antibody at 1:1000 dilution.Secondary antibody: HRP Goat Anti-Rabbit IgG (H+L) at 1:10000 dilution.Lysates/proteins: 25ug per lane.Blocking buffer: 3% nonfat dry milk in TBST.Detection: ECL Basic Kit .Exposure time: 40s.
Immunohistochemistry - ACTL6B Polyclonal Antibody
Immunohistochemistry of paraffin-embedded human kidney using ACTL6B antibody at dilution of 1:100 (40x lens).

Immunohistochemistry - ACTL6B Polyclonal Antibody
Immunohistochemistry of paraffin-embedded human kidney cancer using ACTL6B antibody at dilution of 1:100 (40x lens).

Immunohistochemistry - ACTL6B Polyclonal Antibody
Immunohistochemistry of paraffin-embedded mouse jejunum using ACTL6B antibody at dilution of 1:100 (40x lens).

Immunofluorescence - ACTL6B Polyclonal Antibody
Immunofluorescence analysis of A-549 cells using ACTL6B antibody .
-
Background
Involved in transcriptional activation and repression of select genes by chromatin remodeling (alteration of DNA-nucleosome topology). Component of SWI/SNF chromatin remodeling complexes that carry out key enzymatic activities, changing chromatin structure by altering DNA-histone contacts within a nucleosome in an ATP-dependent manner. Belongs to the neuron-specific chromatin remodeling complex (nBAF complex), as such plays a role in remodeling mononucleosomes in an ATP-dependent fashion, and is required for postmitotic neural development and dendritic outgrowth. During neural development a switch from a stem/progenitor to a postmitotic chromatin remodeling mechanism occurs as neurons exit the cell cycle and become committed to their adult state. The transition from proliferating neural stem/progenitor cells to postmitotic neurons requires a switch in subunit composition of the npBAF and nBAF complexes. As neural progenitors exit mitosis and differentiate into neurons, npBAF complexes which contain ACTL6A/BAF53A and PHF10/BAF45A, are exchanged for homologous alternative ACTL6B/BAF53B and DPF1/BAF45B or DPF3/BAF45C subunits in neuron-specific complexes (nBAF). The npBAF complex is essential for the self-renewal/proliferative capacity of the multipotent neural stem cells. The nBAF complex along with CREST plays a role regulating the activity of genes essential for dendrite growth. ACTL6B/BAF53B is not essential for assembly of the nBAF complex but is required for targeting the complex and CREST to the promoter of genes essential for dendritic growth (By similarity).
Related Products / Services
Please note: All products are "FOR RESEARCH USE ONLY AND ARE NOT INTENDED FOR DIAGNOSTIC OR THERAPEUTIC USE"
